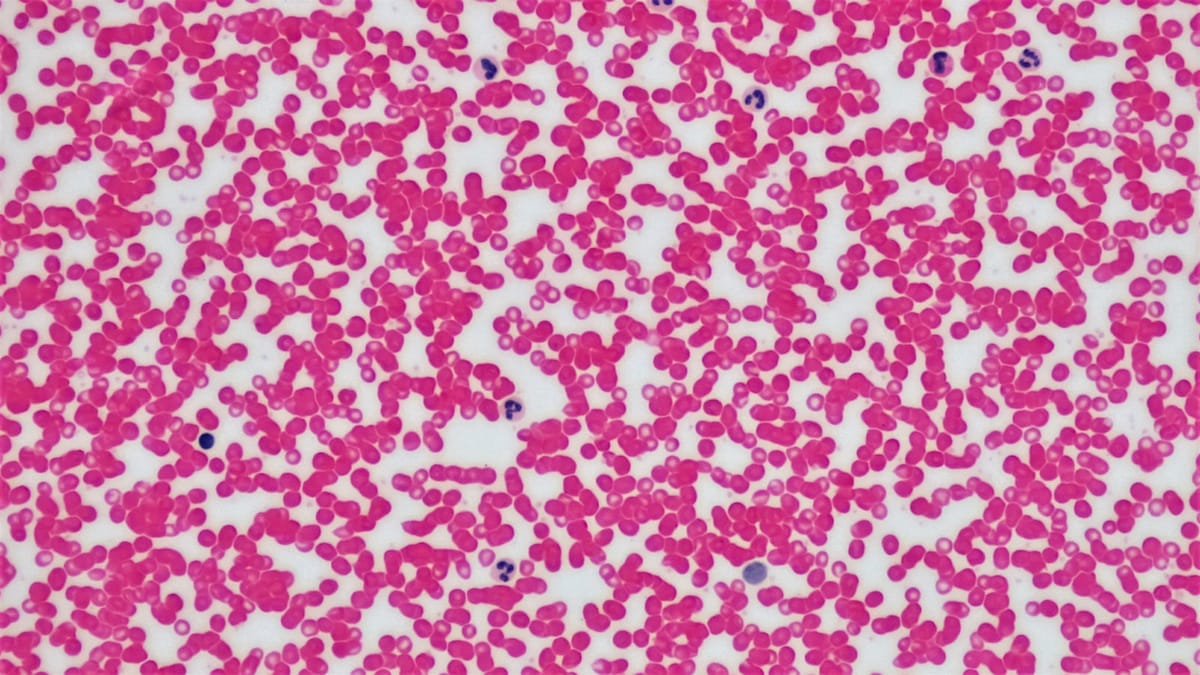
Porozumenie Sickle Cell kríze: VOC, ACS a núdzové stavy

Porozumenie Sickle Cell kríze: VOC, ACS a núdzové stavy
Porozumenie krízam pri ochorení kosáčikovitých buniek (VOC, ACS) je kľúčové. Včasná analgézia a hydratácia sú dôležité pri liečbe VOC. Pri akútnom hrudnom syndróme sú potrebné saturácia kyslíkom a antibiotiká.
Toto video sa zameriava na vysvetlenie sickle cell kríz a život ohrozujúcich komplikácií, vrátane vaso-okluzívnej krízy (VOC), akútneho hrudného syndrómu (ACS), splenickej sekvestrácie, aplastickej krízy a infekcie. Pochopenie týchto stavov je kľúčové pre včasnú diagnostiku a efektívne liečenie.




